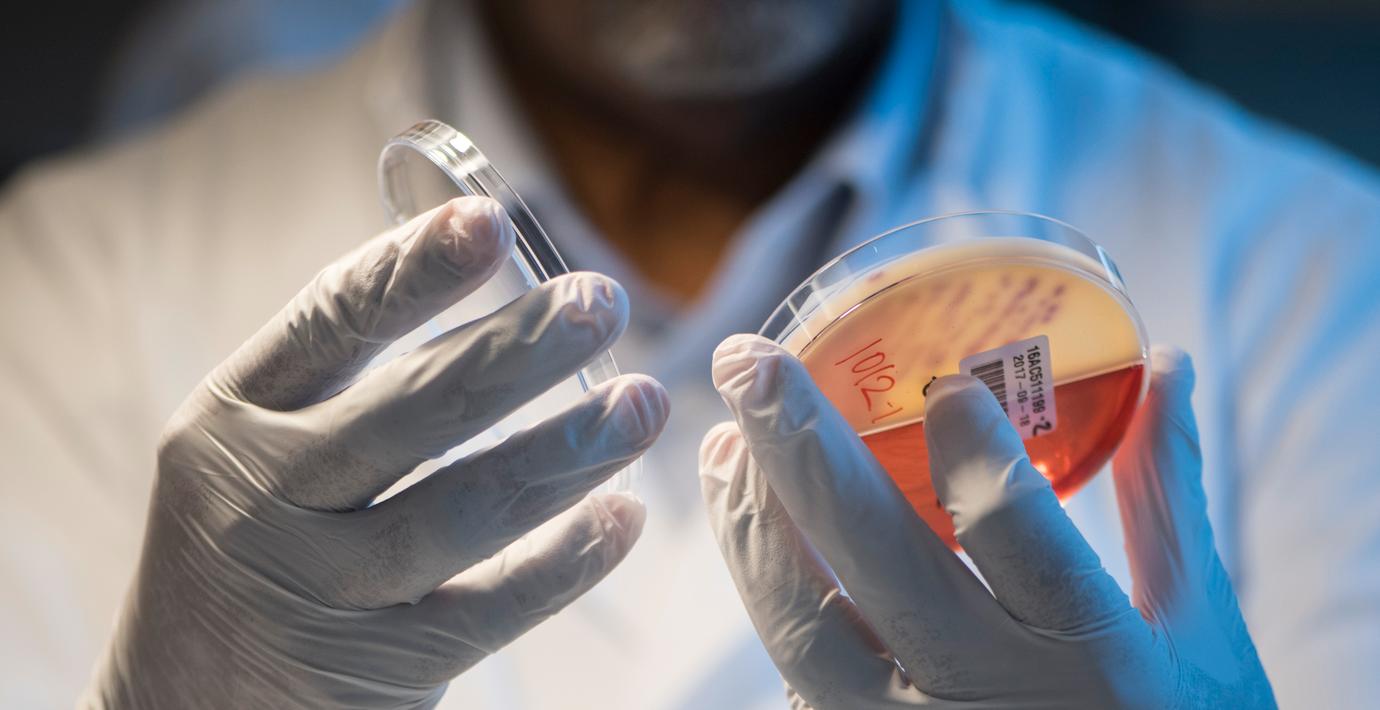

Ledare: Resistenta bakterier lika stort hot som klimatet
Ämnena på söndagens stora ledarsidor varierar. Expressen tar i sin huvudledare upp faran med antibiotikaresistens. Tidningen varnar för att multiresistenta bakterier som uppstår i krigszoner som Gaza och Ukraina kan få spridning – även till Sverige.
”Multiresistenta bakterier skördar redan fler liv än hiv och malaria tillsammans. Hotet måste tas på lika stort allvar som klimatkrisen”.
GP:s Adam Cwejman skriver om de digitala jättarnas allt större makt. Han skriver att samtidens digitala ekonomi allt mer börjar likna ett feodalt system med en jordägande adel.
”Frågan är vilka möjligheter vi har att bryta oss ur det och i vilken mån man kan tala om att det råder konkurrens under dessa förutsättningar”, skriver han.
Sydsvenskans huvudledare handlar om Tidösamarbetet och relationen mellan L och SD. Ledarsidan anser att den nya L-ledaren Simona Mohamsson lurar sig själv när hon öppnar för samarbete med SD:
”Med SD i regeringskansliet är all liberal politik dömd att misslyckas.”
Aftonbladet (oberoende socialdemokratisk):
Dagens Nyheter (oberoende liberal):
Expressen (liberal):
Göteborgs-Posten (liberal):
Svenska Dagbladet (obunden moderat):
Sydsvenskan/Helsingborgs Dagblad (oberoende liberal):
Om ledarsvepet
Omnis ledarsvep utgår från de största ledarsidorna i Sverige. Urvalet varierar dagligen.



